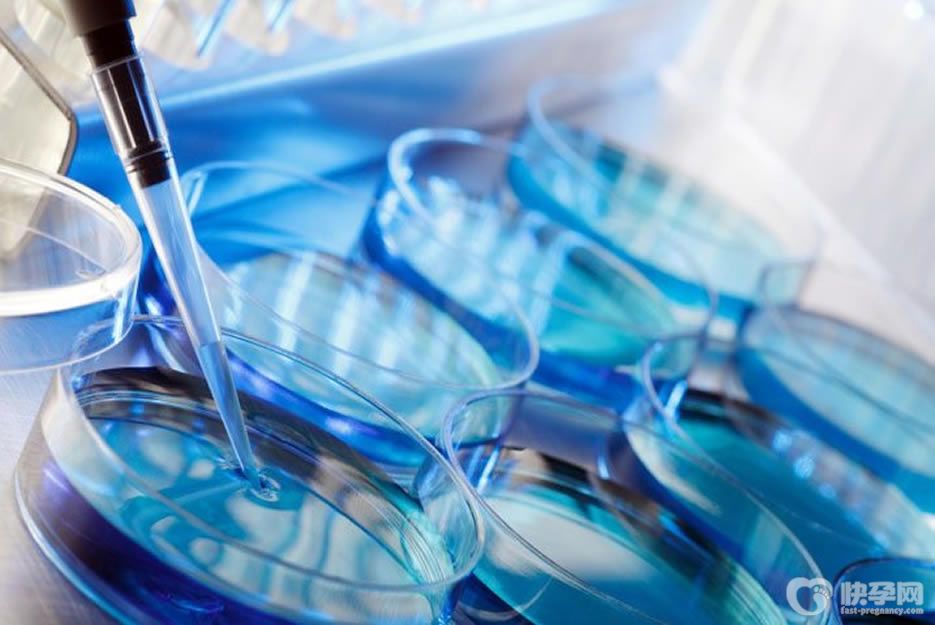

试管婴儿可以做一对儿子吗?视具体情况而定!
- 生殖科普
- 2024-11-24 10:27
试管婴儿可以做一对儿子吗?可能处于位置不同,以及受传统思想影响颇深,备孕无果,或又因传宗接代的思维禁锢,把生儿子的希望放在了试管技术上,一个不够,更想通过试管生一对双胞胎儿子,那做试管时可以选择性别吗?试管婴儿可以做一对儿子吗?今天来给大家进行详细的解答。
试管婴儿可以做一对儿子吗?从两个角度出发,答案并不相同!
二:从法律法规可行性的角度出发,视情况而定
目前,就我国的国情、政策而言,如果不是医学需要,只是由于某些身体原因导致不能生育,或者个人意愿的选择生男生女是禁止的,试管婴儿是不可以选择性别的。
二:从医学角度出发
试管婴儿,是一项科技含量极高的不孕不育治疗方法,其中的第三代试管婴儿技术,是可以做性别鉴定的。
第三代试管婴儿,也称胚胎植入前遗传学诊断(PGD),这项技术能够对他们精、卵形成的胚胎,在放入子宫前,取出胚胎中的一个细胞,通过对23对染色体中的性染色体进行基因和染色体检查,就可以非常可靠地识别胚胎性别。
国家计生委会同卫生部、国家药监局于2002 年11 月29 日,发布了《关于禁止非医学需要的胎儿性别鉴定和选择性别的人工终止妊娠的规定》。
但如果,夫妻双方或一方有遗传病,必须生男生女情况下,做试管婴儿是可以选择性别的。
比如,有严重的家族遗传病,而患病跟下一代性别有关的,类似于那些传男不传女,传女不传男的遗传病。那么,为了避免下一代也患上此病,只要向医院说明情况,是可以在做试管婴儿的时候,凭借相关证明,要求医生筛选胎儿的性别,以确保怀上的是个健康的宝宝。
现在科学技术日新月异,人类也拥有了造物主的”钥匙“,很多人都跑到国外去做第三代试管婴儿选择性别。但是其实人类在拥有造物主“钥匙”的同时,也应该保持敬畏心,保持谦卑,尊重自然,敬重这个世界原本的法则。不管是男宝宝还是女宝宝,既然到来,都是一种缘分不是吗?
总结:试管婴儿可以做一对儿子吗?从两个角度出发,答案并不相同。法律并不允许以选性别的形式做试管婴儿,因为我国明令禁止非医学需要是不能筛查性别的。但如果夫妻双方患有遗传病,但是从实际情况出发,患病和下一代性别有关的,就可以选择性别。所以说,大家不要因为选性别而去做试管,要从实际的情况出发,事实上,孩子的健康才是最重要的,不是吗?

发表评论